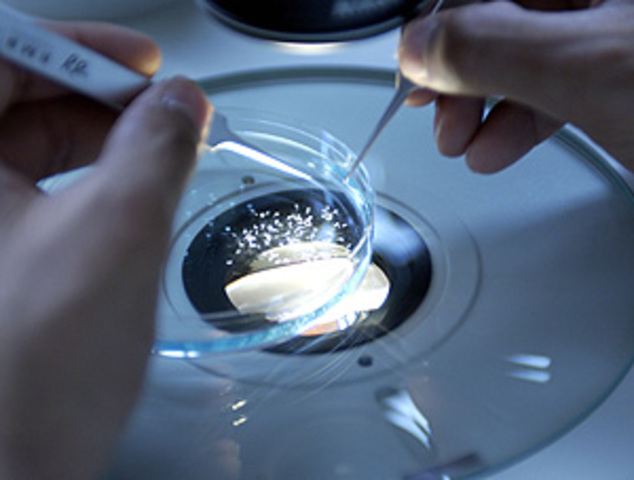
Gripe A

-
-
-
-
-
Nací un 19 de Diciembre de 1994, fue un nacimiento prematuro.
-
-
-
Me bautizaron con casi dos años de edad, y aunque poca gente lo crea, es el primer recuerdo que tengo de mi infancia. Para ser un primer recuerdo, no es algo que lo recuerde ni con alegria ni tristeza, más bien lo recuerdo como un momento extraño para mi y la verdad es que estaba asustada.
-
El primer día de colegio, lo recuerdo con mucho cariño, la etapa en la escuela infantil es de las que más a marcado mi vida y lo que me impulsó a estudiar Magisterio.
-
Nacimiento de mi hermano menor, fué una de las cosas que más me hizo ilusión de pequeña, ya que queria de dejar de ser la menor de casa.
-
Terminé la escuela infantil y nos hicieron una pequeña graduacion
-
Mi primer día de clases en un colegio de mujeres gestionado por monjas, María Auxiliadora.
-
-
-
Terminé el primer año de primaria en el colegio de monjas
-
El segundo año de primaria lo realicé en un colegio mixto privado, llamado "Virgen de la esperanza"
-
-
-
No soy una persona que le guste las religiones, pero mi familia es católica y me obligaron a hacer la comunión; fue por esta época que descubrí que la fé para mi es algo insignificativo y me di cuenta que era atea. Aún asi me obligaron a hacerla, y fue la última vez que me obligaron a hacer algo que de mi no nacía.
-
-
-
-
-
-
terminé mi primaria en el colegio "virgen de la esperanza"
-
Secundaria lo empecé en el mismo colegio en donde terminé primaria.
-
La muerte de mi abuela materna desecandeno una serie de sucesos por los que ahora mismo estoy en españa
-
termino 2 de secundaria en el colegio "virgen de la esperanza", lo recalco porque cuando llegué a España me pusieron en 4 de la eso, por lo tanto no hice 3 de la eso nunca en mi vida.
-
Viajo con mi madre y mis hermanos a España
-
llegamos a Madrid, para mi significó un nuevo comienzo.
-
-
-
-
-
-
-
Me gradue en 4º de la eso un año después de iniciarlo, esto se debe a que no tuve la base de 3º de la eso, por lo que la primera vez que curse 4º de la eso no tenía la base para aprobar.
-
-
Inicié bachillerato de humanidades, ya tenia claro que iba a estudiar magisterio al terminar; a pesar de que antes tenía pensado estudiar una carrera relacionada con medicina, pero como las mates no eran lo mismo opte por otra de las opciones que tenía ya en mente desde pequeña.
-
-
Nace mi sobrina y fui yo quien la cuidó hasta los 7 meses hasta que viajó a Perú
-
Me gradué en bachillerato, pasaba por un momento en el que no quería pasar por la universidad, asi que opte por escoger ir al un ciclo formativo
-
Inicio el ciclo formativo de educación infantil en el instituto Principe Felipe
-
-
-
Uno de los mejores momentos de mi vida, disfrute mucho estando en la escuela infantil y elaborar un proyecto sobre cuentos con mi niños
-
-
-
Fué un viaje relampago, casi no lo habiamos programado. Era la primera vez para nosotros en salir de viaje solo con amigos. Aprovechamos la oportunidad de estar cerca de dos fronteras y conocimos un poco Francia y el centro de Andorra.
-
Me gradué como educadora, mi objetivo era trabajar, pero como sabía que actualmente encontrar trabajo es complicado, y puse la solicitud para entrar a la universidad
-
-
-
atentado Charlie Hebdo
Tiroteo en la sede de Charlie Hebdo, el semanario francés que publicó las caricaturas de Mahoma. -
Hemos vuelto una costumbre ir de viaje entre amigos, aprovechamos el momento para relajarnos desués de la terminar la universidad y estar un tiempo alejado de nuestros padres y sobre todo del calor infernal de madrid.
-
Ha sido una de las experiencias más recientes que he tenido, en esta boda pude conocer más a la familia de mi novio y ellos a mi; se casó la prima de mi novio.
Want to make a timeline like this?
Use Timetoast to turn dates, events, milestones, and phases into a clear visual timeline you can build and share. Timetoast is a timeline maker for work, school, research, and stories.